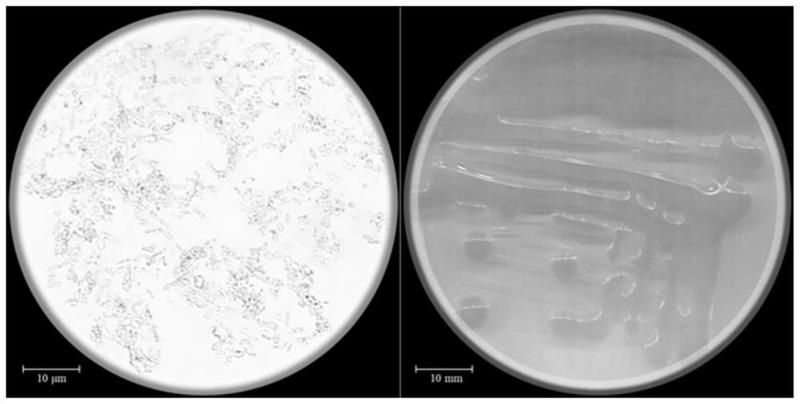
一株大豆根瘤菌及其应用-爱企查

大豆根瘤切片

大科切片试镜——大豆根瘤 - 哔哩哔哩
图片尺寸1256x1256
大豆根瘤切片 植物类装片 根及根的变态 动植物切片 显微镜玻片
图片尺寸487x640
141大豆根瘤切片5x001
图片尺寸800x634
大豆根瘤高校医学院校用组织病理石蜡玻片标本显微镜-阿里巴巴
图片尺寸1080x1080
大豆根瘤切片 植物类装片 根及根的变态 动植物切片 显微镜玻片
图片尺寸750x750
大豆根瘤切片 植物类装片 根及根的变态 动植物切片 显微镜玻片
图片尺寸400x483
教学玻片 大豆根瘤切片 生物显微镜实验切片 教学仪器 植物切片
图片尺寸960x960
大豆根图片
图片尺寸450x300
显微观察-植物幼根横切(单子叶)
图片尺寸3100x1945
1.毛茛根的横切片观察表皮,皮层,维管柱2.
图片尺寸1442x1080
根瘤菌在空间特殊环境下的变化研究团队将其送上太空根瘤菌是大豆进
图片尺寸1080x608
根瘤和蚕豆根横切
图片尺寸480x360
该研究发现根瘤菌trna衍生的小rna片段(trfs)能够在根瘤中劫持大豆
图片尺寸490x387
一株大豆根瘤菌及其应用-爱企查
图片尺寸800x404
大豆根图片
图片尺寸450x300
黄豆茎横切微生物标本显微镜生物切片高校教学实验仪器科研玻片
图片尺寸1080x1080
一种豆科植物根瘤组织原生质体的制备方法与流程
图片尺寸390x594
下图为大豆的根瘤断面.右侧为正常的根组织,左侧为根瘤内部结构.
图片尺寸450x423
新浪绍兴中小学生研学部落优秀作品之潘成屹同学显微镜摄影展
图片尺寸550x548
大豆根图片
图片尺寸450x300